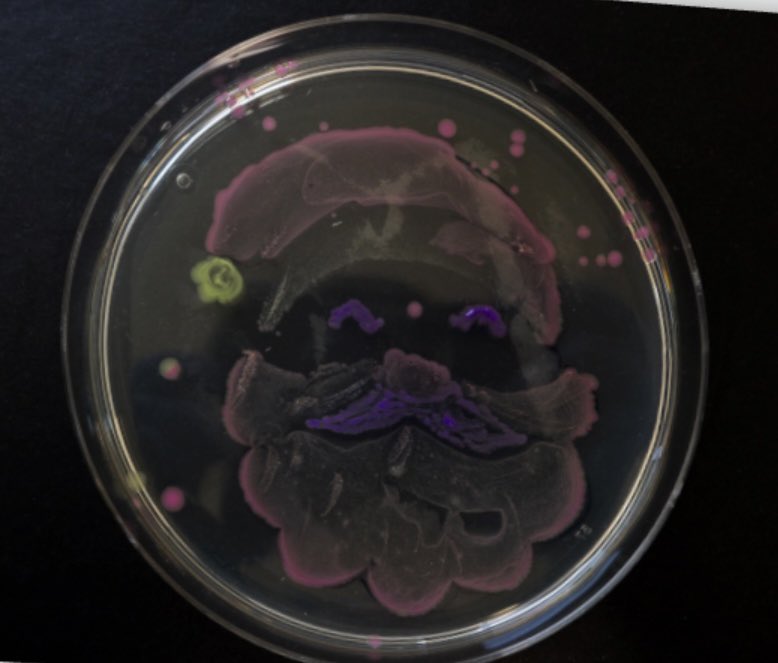
University of Southampton Technicians tweet media

Job Opportunity at the University of Southampton: Biomedical Engineering Teaching Laboratory Supervisor (Maternity cover) jobs.soton.ac.uk/3374826FP
English
University of Southampton Technicians
564 posts

@SotonTechs
Official account for the Technician Network at the University of Southampton. @unisouthampton #TechniciansMakeitHappen #TechsCommit